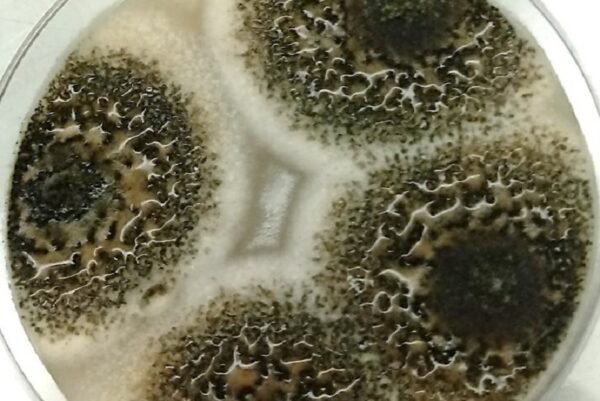

Por primera vez en la Argentina, estudian el estadio reproductivo sexual del hongo que causa la rabia o tizón del garbanzo, una de las enfermedades más destructivas a escala mundial. Desde el Instituto de Investigación Patología Vegetal del CIAP – INTA destacan que se trata de información de gran relevancia para los productores y fitomejoradores de garbanzo.
La rabia o tizón del garbanzo es la enfermedad más destructiva que padece el cultivo a escala mundial. Es causada por el hongo Ascochytarabiei y afecta todas las partes aéreas de la planta: hojas, tallos, pecíolos, vainas y semillas. Es capaz de causar pérdidas de rendimiento hasta del 100%, como se observó en algunos lotes luego del primer reporte en Argentina, en el año 2012.
Hasta el momento, en el país, solo se había reportado el estadio reproductivo asexual (anamorfo) de este hongo y no existen antecedentes relacionados al estudio del desarrollo de la etapa sexual en Argentina.
En este sentido, el Instituto de Patología Vegetal del INTA, cuyos investigadores trabajan con este patosistema desde el 2013, propuso realizar la primera investigación sobre la fase sexual en la Argentina, con resultados de alta relevancia tanto para productores como para fitomejoradores, ya que se concluyó que el estadio reproductivo sexual (teleomorfo) podría ocurrir en la provincia de Córdoba, importante zona productora de garbanzo de Argentina.
“La reproducción sexual de A. rabiei involucra la unión de cepas compatibles. La compatibilidad reproductiva está determinada por el “grupo o tipo de apareamiento” al cual pertenecen dichas cepas. En este caso presenta dos formas alternativas, es decir, “dos tipos de apareamiento o mating-types y para el desarrollo del teleomorfo, ambos deben estar presentes”, explicó la investigadora del Instituto de Patología Vegetal del INTA, Silvina Pastor.
Y agregó: “A través de análisis moleculares de aislamientos de A. rabiei obtenidos de plantas de garbanzo sintomáticas, recolectadas en lotes de las regiones Norte, Centro y Sur de la provincia de Córdoba, pudimos comprobar que ambos tipos de apareamiento están presentes en la región, por lo tanto la reproducción sexual podría ocurrir. No obstante, también debe ir acompañada por ciertas condiciones ambientales requeridas para que el evento suceda. Por eso es que continuamos con los estudios para avanzar en el tema”.
MÁS INFORMACIÓN AGROPECUARIA CLIQUEÁ AQUí
Es importante señalar que la mayoría de los hongos poseen una fase asexual y otra sexual. La función principal de la etapa asexual es la multiplicación y dispersión de la enfermedad, mientras que la sexual confiere diversidad poblacional y sobrevivencia ante condiciones ambientales adversas.
El hecho de que la etapa sexual pueda ocurrir en la Argentina constituye información de fundamental importancia para los productores. La resistencia a los fungicidas es una de las adaptaciones que podrían ocurrir en las poblaciones recombinantes, como también la eventual emergencia de biotipos del hongo con distintos niveles de virulencia.
“Si esto ocurriera sería particularmente perjudicial porque son pocos los fungicidas que están legalmente registrados para el control de la enfermedad y las variedades comerciales resistentes a la misma aún no están disponibles para los productores”, aseguró la investigadora-becaria doctoral CONICET- Clara Crociara.
Por otra parte, y si se tiene en cuenta que la fase sexual podría ocurrir en la Argentina, el INTA también trabaja en una línea de control biológico de la enfermedad. “Evaluamos in vitro y en ensayo de invernadero nuestras cepas de A. rabiei con diversos aislamientos de Trichoderma spp. candidatos para el control biológico de la enfermedad. También estudiamos el efecto de diferentes aislamientos de bacterias endófitas de garbanzo que podrían mejorar la resistencia frente a la presencia del hongo en la planta infectada”, explicó el investigador Lucio Valetti, quien se encuentra a cargo de los estudios de biocontrol en el Instituto de Patología Vegetal.

Rabia de Garbanzo: una línea de trabajo
Cabe destacar que, a partir de la detección de la rabia del garbanzo, el INTA trabaja en la coordinación y desarrollo de una línea sobre la enfermedad para responder a las necesidades de los productores.
“Es fundamental conocer la calidad sanitaria del garbanzo sembrado, ya que la enfermedad comienza con la introducción de la semilla enferma y sobrevive entre 3 y 4 años, además de incrementar el inóculo en el campo si este ya se encuentra en el rastrojo de garbanzo infectado en campañas anteriores”, señaló Pastor y explicó que “frecuentemente, se siembran semillas desconociendo que son portadoras del patógeno, porque a diferencia de los otros órganos de la planta, estas suelen ser asintomáticas”.
En el marco de la línea Rabia del Garbanzo, el INTA trabajó en temas relacionados al mejoramiento genético, junto a la Facultad de Ciencias Agropecuarias de la Universidad Nacional de Córdoba; como también en el desarrollo de un método molecular de detección temprana en planta, que permite identificar el ADN del patógeno de esta compleja enfermedad cuando sus síntomas aún son indefinidos y se confunden con otros agentes causales de similares sintomatologías, algo que suele ocurrir en la fase temprana.
El método constituye una herramienta de detección de alta sensibilidad y especificidad que conduce a un diagnóstico certero al inicio de la enfermedad, lo que permite tomar decisiones de manejo que minimicen su dispersión y las pérdidas de rendimiento en el cultivo.
“Nos faltaba aún el estudio del desarrollo de la fase sexual de A. rabiei y si bien están en curso investigaciones para monitorear la distribución de los mating-types y la ocurrencia del teleomorfo en los campos de Argentina, este es un gran avance que nos mantiene alerta en relación a una enfermedad tan destructiva como la rabia del garbanzo”, puntualizó Pastor.
Fuente: INTA Informa









































